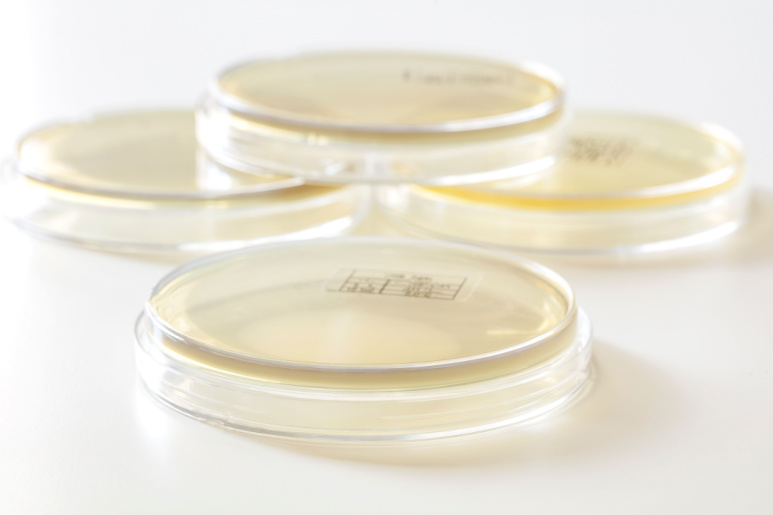

Maintaining a contaminant-free environment is fundamental during the production of pharmaceutical and medical devices. Environmental monitoring plays a crucial role in the manufacturing process to ensure high product quality, compliance with regulatory standards, and the protection of patient safety. During environmental monitoring there are two targets being monitored; Viable and Non-Viable particles. Viable environmental monitoring focuses on the detection and quantification of living microorganisms, whereas non-viable environmental monitoring, on the other hand, assesses overall particle levels and their impact on air quality. Examples of particles include dust, pollen and human skin cells etc.
Through diligent monitoring of the manufacturing environment, particularly critical areas like cleanrooms, companies can effectively identify and control potential sources of contamination. This proactive approach maintains the integrity of pharmaceutical products and also ensures adherence to good manufacturing practices. Furthermore, The new EU GMP Annex 1 revision will come into effect on 25 August 2023. The new revision emphasises the importance of continuous monitoring during critical processes, including aseptic equipment assembly and filling operations. The environmental monitoring process enables risk mitigation, process optimization. It also serves as a tool to aid in the prevention of a manufacturing shutdown, saving significant amounts of time and costs.
There are a number of important tools required to perform environmental monitoring, including:
- Environmental Monitoring Swabs
- Settle Plates
- Environmental Isolates
- Microbial Air Samplers
- Real Time Microbial Monitoring
- Air Particle Monitoring
Environmental Monitoring Swabs

The ability to effectively detect and analyse potential sources of contamination is crucial for pharmaceutical manufacturing. Among the various tools and technologies available, Copan swabs have emerged as a game-changer. These innovative swabs have revolutionized the field, offering reliable and efficient solutions for environmental monitoring. In this blog, we will explore the significance of Copan swabs and how they contribute to maintaining the highest standards of cleanliness and safety.
Copan swabs are specifically designed sampling devices used to collect environmental samples for microbiological analysis. They are engineered with precision, utilizing high-quality materials to ensure accurate sample collection and preservation. These swabs come in various types, including foam, flocked, and traditional cotton, each tailored to specific applications and sampling needs. The innovative design of these swabs maximizes the surface area available for sample collection, enabling better recovery of microorganisms. This efficiency is particularly crucial in critical environments such as cleanrooms, where even minimal contamination can have significant consequences. Copan swabs offer the ability to capture a wide range of microorganisms, including bacteria, fungi, and viruses, ensuring comprehensive environmental monitoring.
Settle Plates
Settle plates serve as a simple yet effective method for environmental monitoring in various industries. These passive sampling devices consist of agar plates that are left open and exposed to the surrounding environment for a specified period. As the plates are left undisturbed, airborne particles and microorganisms settle onto the agar surface. After the sampling duration, the plates are incubated to allow the growth of any captured microorganisms, which can then be analysed and identified.
Settle plates offer several advantages for environmental monitoring. Firstly, they provide a cost-effective and easy-to-use solution, requiring minimal equipment and setup. This makes settle plates accessible for routine monitoring in a range of settings, including cleanrooms, healthcare facilities, and food processing areas. Additionally, settle plates allow for the collection and identification of a broad range of microorganisms, including bacteria, fungi, and yeasts. By analysing the microbial colonies grown on the agar plates, potential sources of contamination can be identified, enabling prompt corrective actions to be taken. While settle plates have certain limitations, such as the inability to measure airborne particle concentrations, they remain a valuable tool in environmental monitoring, offering a practical and informative method for assessing microbial contamination levels in various environments.
Environmental Isolates
Environmental isolates, which are microorganisms collected from the manufacturing environment, serve as a powerful tool in the pharmaceutical sector. These isolates play a crucial role in understanding and managing the microbial composition within pharmaceutical facilities. By analysing these microorganisms, pharmaceutical companies gain valuable insights into the types, quantities, and characteristics of microorganisms present in their manufacturing environments.
The analysis of environmental isolates allows companies to detect potential contaminants that may compromise product quality or patient safety. Furthermore, environmental isolates provide a means for assessing the overall microbiological health of pharmaceutical facilities. By evaluating the diversity and prevalence of microorganisms, companies can assess the effectiveness of their cleaning and disinfection practices.

MSC, in conjunction with our partner Microbiologics, provide a turnkey professional preservation service to pharmaceutical microbiology laboratories called Microbiologics Custom Solutions. Microbiologics Custom Solutions service is designed to make the use of environmental isolates just as convenient, easy, and precise as using any of our ready-to-use formats for QC testing.
With our service, you can send your environmental isolate strain to our facility, we’ll identify, preserve, and manufacture it in an easy-to-use format that meets your laboratory’s needs.
With this service you will enjoy a range of advantages, including:
- Cost-savings
- ISO accredited test-ready controls
- Finished goods storage
- Product warranty
- Confidence in your product’s safety
Microbial Air Sampler

Microbial air samplers play a crucial role in maintaining the safety and sterility of environments where microbial contamination can have serious consequences. They are specifically designed to capture and analyse airborne microorganisms. Microbial air samplers employ various sampling techniques, such as impaction, impingement, or filtration, to collect microorganisms present in the air onto a growth medium or collection surface. The collected samples are then analysed in the laboratory to identify and quantify the microbial species present. This information allows for the assessment of microbial levels and the detection of any potential pathogens or unwanted microorganisms that may compromise the safety and quality of the environment.
The PMT Hyclas Microbiological Air Sampler is a high performance portable microbial air sampler suitable for use in clean rooms and aseptic environments. Some of the great features of the Hyclas include:
- Screw-less design for easy cleaning and minimising contamination
- Electropolished 316L grade stainless steel
- Air exhaust parallel to the sampling path resulting in no turbulence being generated
- Compact & Portable (weight <2.5 kg)
- 100 litres sampled per minute
- Removable rechargeable batteries
Real Time Microbial Monitoring
The TSI BioTrak is a state-of-the-art environmental monitoring system developed to provide comprehensive insights into microbial contamination. It combines advanced technologies and proprietary algorithms to detect, identify, and quantify airborne particles and microorganisms in real-time.

Unlike traditional methods that require time-consuming laboratory analysis, BioTrak instantly collects and analyses data on airborne particles. The distinctive feature of the Biotrak is its ability to differentiate between viable and non-viable particles. Through laser-induced fluorescence and spectroscopy, the system analyses the fluorescence signatures and spectral characteristics of airborne particles. Viable particles, such as living microorganisms, exhibit specific fluorescence and spectral patterns due to metabolic activity and cellular components. In contrast, non-viable particles, such as dust or debris, display different characteristics. By leveraging these distinctive features, BioTrak can accurately distinguish between viable and non-viable particles.
BioTrak’s advanced built-in algorithms and data visualization tools provide powerful insights for data-driven decision-making in real-time. This enables rapid detection of contamination events, allowing for swift response and mitigation measures to be implemented. This real-time monitoring capability empowers companies to make informed decisions based on accurate and up-to-date information, enhancing overall operational efficiency, quality control, and regulatory compliance.
Particle Monitoring
Particle counters find extensive application in industries such as pharmaceuticals and semiconductor manufacturing for the detection of non-viable particles.

One of the key advantages of the PMT AeroTrak is its real-time monitoring capability. The monitors provide instantaneous feedback on particle levels, allowing users to quickly identify any deviations from desired cleanliness standards. This real-time data empowers cleanroom operators to take immediate corrective actions and ensuring continuous compliance with the Annex 1 regulatory requirements. AeroTrak particle monitors also offer comprehensive data logging and reporting features. They can store and analyse data over extended periods, enabling trend analysis, retrospective investigations, and regulatory compliance audits.
Features of the AeroTrak-Plus include:
- Configured for Annex 1 compliance
- Sampling duration: 1 second – 24 hours, or continuous
- 100L/min flow rate, 0.5 – 10 μm
- Traffic light status display – LED light bar visible from 20 meters
- Multi-level user access with audit trail
- Industry-leading 5-year laser warranty
- Fully cleanable, 316 stainless steel housing
- Report generation with TrakPro™ Lite Secure Software (free of charge)
If you would like more information on any of our environmental monitoring solutions, fill out the form below.
Get in touch


